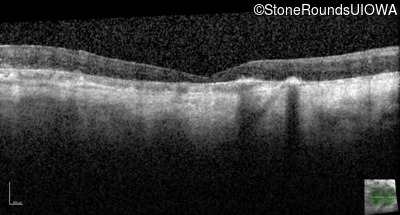
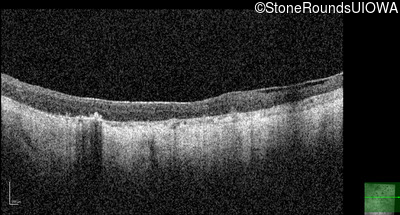

Case
SR568
Student Mode
AR Retinitis Pigmentosa (IA1aiii)
Female
Female
Hidden
SR568
Student Mode
AR Retinitis Pigmentosa (IA1aiii)
Female
Female
Highlighted Images
| Age at visit: 61 years | OD | OS |
|---|---|
| Age at visit: 25 years |
| Age at visit: 37 years |
| OD | OS | ||
|---|---|---|---|
| Age at visit: 39 years |
| OD | OS | ||
|---|---|---|---|
| Age at visit: 42 years |
| Age at visit: 51 years |
| Age at visit: 61 years |
| Age at visit: 65 years |
| Age at visit: 67 years |
| Age at visit: 70 years |
| Age at visit: 72 years |
| Age at visit: 74 years |
| Age at visit: 76 years |
Diagnosis & molecular findings
| Disease | Gene | Allele 1 variant(s) | Allele 2 variant(s) | Inheritance mode |
|---|---|---|---|---|
| AR Retinitis Pigmentosa | CDHR1 | Gln175 ins1cA | IVS12-1 G>A | AR |
Disease:
Gene:
Allele 1:
Gln175 ins1cA
Allele 2:
IVS12-1 G>A
Inheritance:
AR